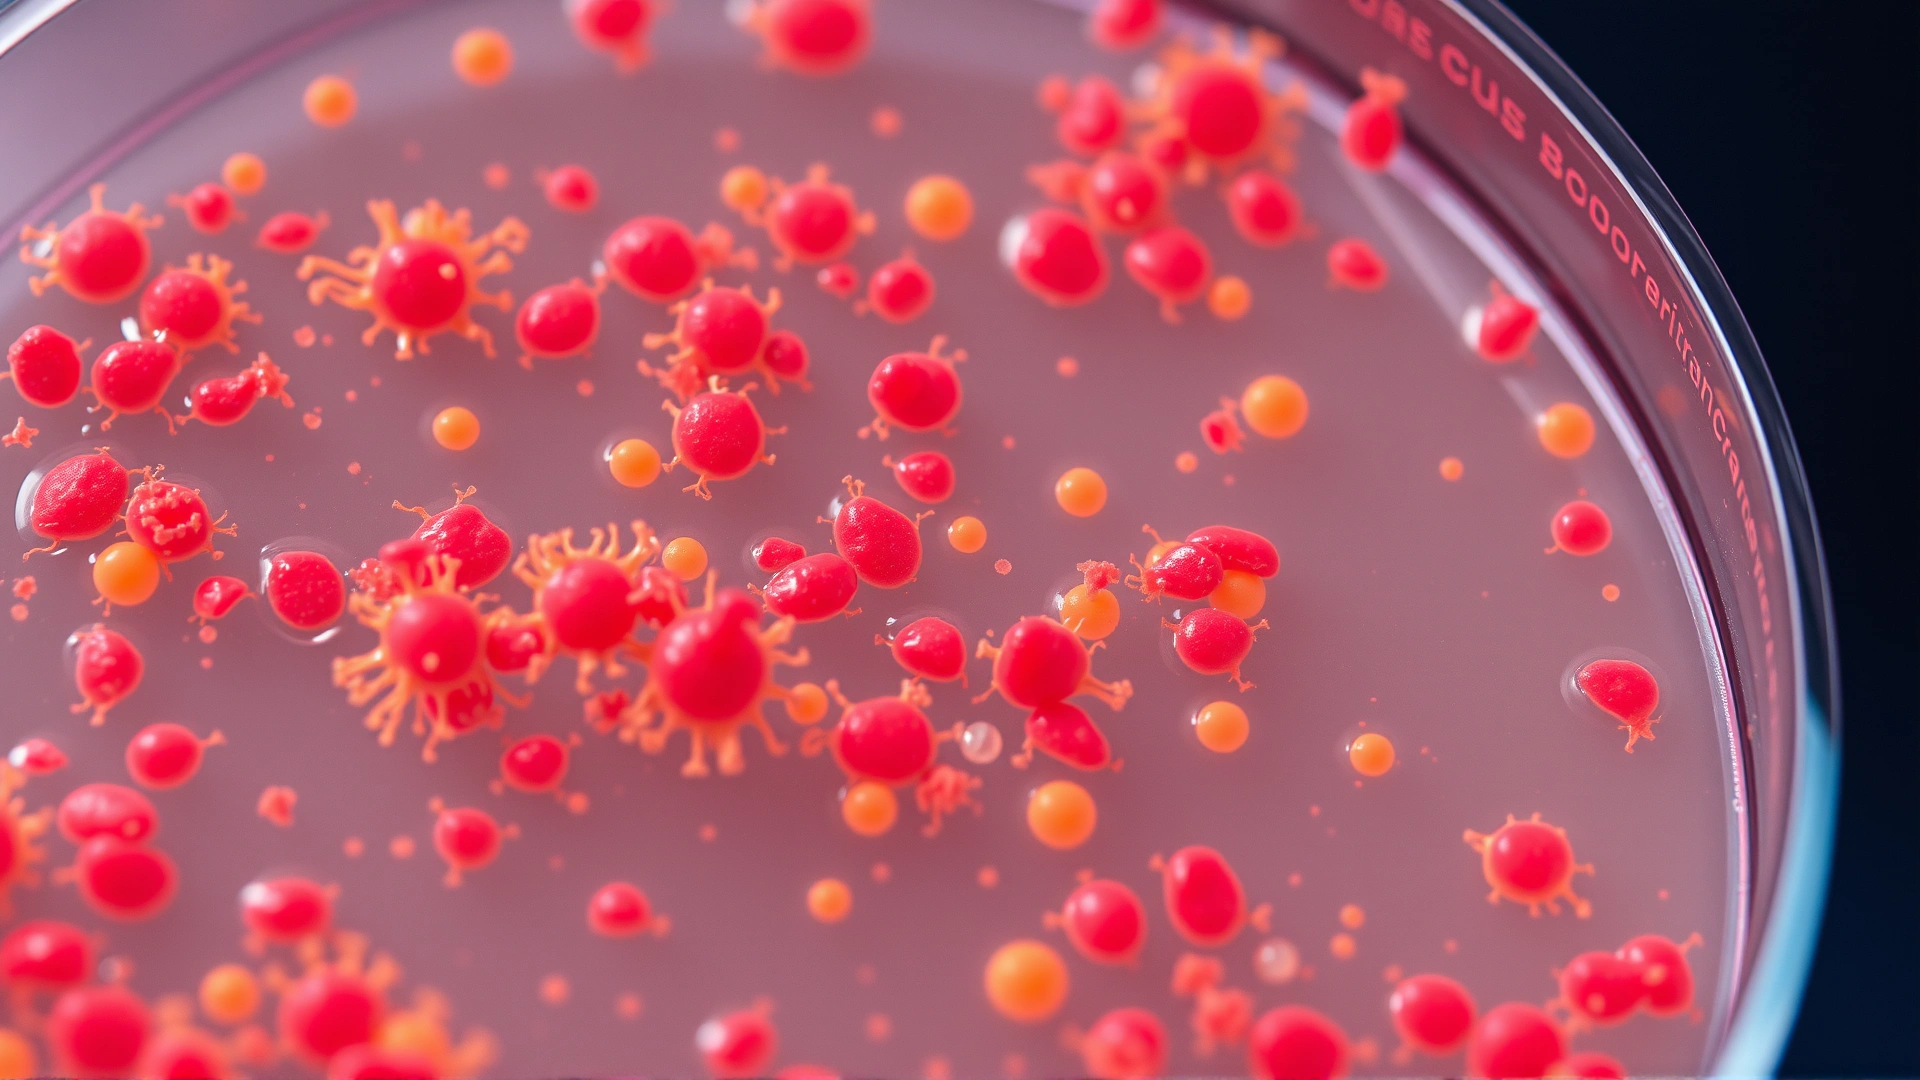
Close-up of a laboratory petri dish containing staphylococcus aureus bacterial colonies on agar, vivid colors

أشياء مخيفة قد تختبئ في سرير كلبك
قد لا يخطر ببالك وأنت ترى كلبك يلتف بسعادة فوق وسادته المفضلة أن هذا السرير الصغير يمكن أن يكون مرتعًا للعديد من الطفيليات والجراثيم الخطرة. تُعَدّ معرفة ما يعيش مع كلبك الخطوة الأولى للحفاظ على صحته وصحة أفراد أسرتك، لذلك جمعنا لك أهم «الضيوف غير المرغوب فيهم» الذين قد يختبئون في ألياف سرير الكلب وكيفية التعامل معهم.
لماذا يجب أن نهتم بنظافة سرير الكلب؟
يقضي الكلب ما بين 10 إلى 14 ساعة يوميًا في النوم، ما يجعل سريره مساحة مثالية لتراكم البكتيريا، والرطوبة، وبقايا الجلد، وأغلفة الطفيليات. إذا تُرك السرير دون تنظيف منتظم، يمكن لهذه الملوثات أن تتكاثر وتنتقل ليس فقط إلى الكلب، بل إلى أفراد العائلة أيضًا، مسبِّبة التهابات جلدية أو أمراضًا أكثر خطورة.
10 مخاطر شائعة قد تعيش في سرير كلبك
البراغيث
البراغيث هي أكثر الطفيليات الخارجية شيوعًا لدى الكلاب. يمكن لبرغوث واحد أن يضع ما يصل إلى 50 بيضة يوميًا داخل سرير الكلب، لتفقس لاحقًا وتُعيد دورة العدوى. تُسبب البراغيث حكة شديدة، وحساسية جلدية، وأحيانًا فقر دم لدى الجراء الصغيرة.
منتجات موصي بها من متجر حيواناتي:

القراد
يتشبث القراد بجلد الكلب لتتغذى على دمه، ثم تسقط غالبًا داخل سريره عندما تكتفي. يحمل القراد مسبِّبات أمراض خطيرة مثل داء لايم والحمّى القرادية. وجود قراد واحد فقط يكفي لنقل العدوى.
منتجات موصي بها من متجر حيواناتي:

حشرات الفراش
لا يقتصر وجود بقّ الفراش على أسِرّة البشر؛ إذ يمكنه الاختباء في أي نسيج دافئ بما في ذلك سرير الكلب. لسعاته لا تحمل أمراضًا خطيرة عادة، لكنها تُسبِّب حكة شديدة وقلقًا في النوم لكلبك ولعائلتك.

عث الغبار
هذه الكائنات المجهرية تتغذى على خلايا الجلد الميتة وتُعَدّ من أبرز مسبِّبات الحساسية في المنازل. يمكن للعث أن يُفاقم أعراض الحساسية والربو لدى البشر والحيوانات.
منتجات موصي بها من متجر حيواناتي:

القمل
على الرغم من ندرته مقارنة بالبراغيث، فإن القمل قد يصيب الكلاب الصغيرة أو الضعيفة مناعيًا. يتكاثر القمل بسرعة ويُسبِّب حكة شديدة وتساقطًا للشعر.

الفطريات (السعفة)
السعفة ليست دودة بل عدوى فطرية تُصيب الجلد والأظافر. يمكن أن تعيش أبواغها في الأقمشة لفترات طويلة، وتنتقل بسهولة إلى البشر، ما يجعل تنظيف السرير وتعقيمه أمرًا بالغ الأهمية عند ظهور أي بقع جلدية دائرية على كلبك.

البكتيريا العنقودية الذهبية (Staph) ومقاومة المضادات الحيوية (MRSA)
الأسطح الرطبة والدافئة تُشكِّل بيئة مثالية للبكتيريا العنقودية. إذا كان الكلب مصابًا بعدوى جلدية، فقد تنتقل البكتيريا إلى سريره ومنها إلى جلدك عند ملامسته. بعض السلالات مقاومة للمضادات الحيوية، ما يجعل القضاء عليها أكثر صعوبة.

بيوض الديدان المعوية
الكثير من الديدان (مثل الأسطوانيات والشريطيات) تضع بيوضها في براز الكلب، وقد تنتقل هذه البيوض إلى السرير عن طريق الشعر أو الأقدام. يمكن أن تعيش البيوض لأسابيع وتُصيب الكلب مجددًا أو تنتقل للأطفال.
منتجات موصي بها من متجر حيواناتي:

غبار الطلع ومسبِّبات الحساسية الأخرى
قد يحمل الكلب في فروه حبوب لقاح، وعفنًا، وشعر حيوانات أخرى، فتلتصق بأقمشة السرير. هذه الجزيئات الصغيرة قد تُهيِّج الجهاز التنفسي لمن يعانون من الحساسية.
منتجات موصي بها من متجر حيواناتي:

العفن والرطوبة
الأسرّة التي تُغسل ولا تُجفف جيدًا تشكِّل تربة خصبة للعفن. استنشاق أبواغ العفن قد يُسبِّب مشاكل تنفسية مزمنة للكلب ولصاحب المنزل.

كيف تُبقي سرير كلبك نظيفًا وآمنًا؟
- الغسل الأسبوعي بالماء الساخن: يساعد الماء بدرجة 60° مئوية أو أكثر على قتل معظم الطفيليات والجراثيم.
- التجفيف على حرارة عالية: يُفضَّل استخدام المجفف بدل التجفيف الهوائي للقضاء على البراغيث وبيوضها.
- استخدام أغطية قابلة للخلع: اختر سريرًا بغطاء سحّاب ليسهل خلعه وغسله باستمرار.
- العلاج الوقائي للطفيليات: استشر البيطري لوصف أدوية شهرية ضد البراغيث والقراد.
- الكنس والتهوية: نظِّف أرضية المكان حول السرير بالمكنسة الكهربائية، وافتح النوافذ لدقائق يوميًا لتقليل الرطوبة.
- فحص الكلب بعد النزهات: ابحث عن أي براغيث أو قراد على الفور قبل أن يجد طريقه إلى السرير.
تذكّر: سرير نظيف يساوي كلبًا صحيًا وبيتًا أكثر أمانًا.
الخلاصة
تنظيف سرير كلبك بانتظام ليس مهمة تجميلية وحسب، بل هو خط دفاع ضروري ضد طفيليات وبكتيريا قد تضر بالجميع. باتباع الخطوات السابقة ستكون قد قطعت شوطًا طويلًا نحو الحفاظ على صحة كلبك وأسرتك.

المراجع
- فلسفة الرعاية الحيوانية. “الكلاب والحساسية المنزلية.” , 2021-10-15. www.akc.org